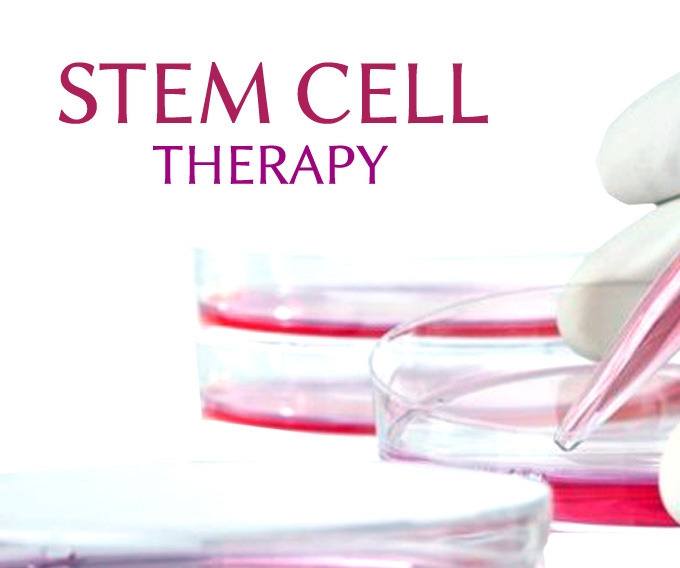

제9화 줄기세포로 기억을 되살릴 수 있을까?
재생의학의 가능성
우리는 모두 한 번쯤 이런 상상을 해봅니다.
“혹시 내 기억을 잃는다면, 다시 되찾을 수 있을까?”
알츠하이머병과 같은 치매는 기억이라는 인간의 정체성을 무너뜨리는 병입니다. 가족의 얼굴을 잊고, 오래된 추억이 하나씩 사라지는 모습을 지켜보는 것은 환자뿐만 아니라 곁에 있는 이들에게도 큰 아픔이지요. 최근에는 ‘줄기세포 치료’가 이러한 상황을 바꿀 수 있을지도 모른다는 희망을 주고 있습니다.
 줄기세포는 인체의 모든 조직을 재생할 수 있는 능력이 있습니다.
줄기세포는 인체의 모든 조직을 재생할 수 있는 능력이 있습니다.줄기세포란 무엇인가?
줄기세포는 우리 몸의 여러 종류의 세포로 분화할 수 있는 특별한 세포입니다. 쉽게 말해, 다양한 역할을 맡을 준비가 된 “만능 세포” 같은 존재지요. 손상된 조직이 있을 때, 줄기세포는 그 빈자리를 채울 새로운 세포로 변할 수 있습니다.
줄기세포는 그 출처와 생성 방식에 따라 크게 네 가지로 나눌 수 있습니다: 배아줄기세포(Embryonic Stem Cell, ESC), 성체줄기세포(Adult Stem Cell), 제대혈 줄기세포 (Umbilical Cord Blood Stem Cell), 유도만능줄기세포(Induced Pluripotent Stem Cell, iPSC)가 있습니다. 각각의 특성과 만들어지는 과정은 다음과 같습니다..
1. 배아줄기세포 (Embryonic Stem Cell, ESC)
배아줄기세포는 수정 후 약 5일이 지난 배아(‘배반포, blastocyst’ 단계)의 내부세포괴(inner cell mass, ICM)에서 얻습니다. 배아줄기세포를 만들기 위해서는 우선 시험관 수정으로 배아를 형성합니다. 그리고 5~6일 후 배반포(blastocyst) 단계에서 내부세포괴 (Inner Cell Mass, ICM)를 분리합니다. 이 세포들을 특수한 배양 조건에서 키우면, 무한히 분열하며 여러 조직으로 분화 가능한 줄기세포(pluripotent stem cells)를 얻을 수 있습니다. 배아줄기세포는 모든 조직(신경, 심장, 간, 근육 등)으로 분화할 수 있는 강력한 잠재력이 있지만, 배아를 파괴해야 한다는 점에서 윤리적 논란이 큽니다.
2. 성체줄기세포 (Adult Stem Cell)
성체줄기세포는 성인의 다양한 조직(골수, 지방, 피부, 치아, 제대혈 등)에 존재합니다. 성체줄기세포를 만들기 위해서는 우선 환자의 조직(예: 골수 흡인, 지방조직 흡인 등)에서 줄기세포를 채취합니다.그런 다음 실험실에서 필요한 세포만 선별하고, 증식시켜 치료에 사용합니다.
하지만 모든 조직으로 분화할 수있는 배아줄기세포와는 달리 성체줄기세포는 특정 조직으로만 분화할 수 있는 제한적 분화능(multipotent)을 가집니다. 예를들어 조혈줄기세포는 혈액세포로만 분화하고, 중간엽줄기세포는 뼈, 지방, 연골 등으로만 분화합니다. 성체줄기세포의 장점은 윤리적 문제가 적고 자기 세포를 쓰면 면역 거부반응도 줄일 수 있다는 점이 있습니다.
3. 제대혈 줄기세포 (Umbilical Cord Blood Stem Cell)
제대혈 줄기세포는 신생아 탯줄 혈액에서 얻습니다. 이곳에는 조혈줄기세포 (Hematopoietic Stem Cell,HSC)가 풍부합니다. 조혈줄기세포는 말 그대로 혈액을 만드는 줄기세포를 말합니다. 조혈줄기세포는 거의 모든 혈액세포(적혈구, 백혈구, 혈소판 등)로 분화할 수 있습니다. 따라서 백혈병, 림프종, 재생불량성 빈혈 같은 혈액질환 치료에 활용될 수 있습니다.
4. 유도만능줄기세포 (Induced Pluripotent Stem Cell, iPSC)
유도만능줄기세포(iPSC)는 피부세포나 혈액세포처럼 이미 분화가 끝난 체세포에서 얻습니다.
유도만능줄기세포는 말 그대로 배아줄기세포와 마찬가지로 모든 조직으로 분화 할 수 있는 만능 줄기세포 입니다. 유도만능줄기세포는 환자의 체세포에 예를들어 피부 섬유아세포에 네 가지 특정 전사인자(Oct4, Sox2, Klf4, c-Myc, 흔히 ‘야마나카인자’)를 유전자 도입해 세포의 운명을 리프로그래밍(reprogramming)합니다. 그러면 환자의 체세포가 시간을 가꾸로 돌려 줄기세포 시절로 돌아가는 '마법'과 같은 일이 발생합니다. 이렇게 하면 성체 세포가 다시 ‘배아줄기세포 수준’의 만능성(pluripotency)을 가지게 됩니다. 그러면 이 유도만능줄기세포는 다시 모든 세포로 분화 할 수 있는 상태가 되는 것입니다.
유도만능줄기세포의 특징은 인간의 배아를 파괴하지 않고 ESC(배아줄기세포)와 유사한 능력을 지닌 만능 줄기세포를 만들 수 있다는 점에서 윤리적 문제를 해결했습니다. 유도만능줄기세포는 환자의 세포에서 추출해서 만들어 지기 때문에 면역거부 반응도 최소화할 수 있어 맞춤형 치료가 가능합니다.
과학자들은 바로 이 특성을 이용해, 손상된 뇌 신경세포를 대체하거나 회복시키는 방법을 연구하고 있습니다. 예를 들어 알츠하이머 환자의 뇌에 줄기세포를 이식하면, 새로 태어난 신경세포가 기존 회로망과 연결되며 뇌 기능 회복에 도움을 줄 수 있다는 것이죠.
다만, 아직까지는 유전자 조작 과정에서 암 발생 위험 등이 있어 임상 적용에는 신중해야 합니다.
줄기세포 치료의 가능성
사람의 뇌신경세포(뉴런)는 성인이 된 이후에는 거의 재생되지 않습니다. 특히 대뇌피질의 뉴런은 손상되면 스스로 회복하기 어렵습니다. 그래서 뇌졸중, 알츠하이머병, 파킨슨병과 같은 뇌질환은 한번 손상되면 치료할 수 없는 “비가역적”이라고 불려왔지요. 줄기세포 치료는 이런 한계를 극복하려는 시도로 연구되고 있습니다. 줄기세포는 다양한 세포로 분화할 수 있는 능력이 있기 때문에, 연구자들은 이를 신경세포(뉴런)나 신경교세포로 유도하여 뇌 속에 이식하려 합니다.
줄기세포 치료의 가능성은 크게 세 가지 측면에서 이야기할 수 있습니다. 첫째, 줄기세포는 새로운 신경세포(뉴런)로 분화할 수 있어 손상된 뇌세포를 대체하고, 일부 회로망의 기능을 다시 이어줄 수 있는 잠재력을 가지고 있습니다. 이는 마치 끊어진 전선을 새로운 전선으로 갈아 끼워 다시 전기가 통하게 하는 것과 비슷한 개념입니다.
둘째, 줄기세포는 단순히 세포를 공급하는 것에 그치지 않고, 뇌 속에서 다양한 신경영양因자(neurotrophic factor)를 분비해줍니다. 이 인자들은 이미 남아 있는 신경세포들이 더 오래 살아남고 서로 연결을 강화할 수 있도록 돕습니다. 즉, 새로운 세포를 심어주는 동시에 기존 세포의 “건강 관리” 역할도 해내는 것입니다.
셋째, 줄기세포는 면역과 염증 조절에서도 중요한 역할을 합니다. 줄기세포가 미세아교세포(microglia)나 별아교세포(astrocyte)로 분화하면, 뇌 속에서 과도하게 일어나는 염증 반응을 완화하고 손상된 조직의 회복을 지원할 수 있습니다. 이는 곧 병든 환경을 정리해 새로운 세포들이 자리 잡기 좋은 터전을 마련하는 과정이라 할 수 있습니다.
현재 연구 단계에서는 동물실험을 통해 줄기세포 이식 후 일부 기억 기능이 회복되거나 운동 능력이 개선되는 긍정적인 결과들이 보고되고 있습니다. 그러나 사람에게 적용했을 때는 여전히 여러 한계가 존재합니다. 이식된 줄기세포가 뇌 속에서 안정적으로 살아남고, 올바른 위치에 정착하며, 무엇보다 복잡한 뇌 회로망을 제대로 형성할 수 있을지는 아직 확실하지 않습니다.
실제로 일부 임상시험이 진행 중이긴 하지만, 아직 줄기세포 치료가 알츠하이머병이나 치매 같은 뇌질환을 “완전히 치료하는 방법”으로 자리 잡기에는 초기 단계에 머물러 있습니다.
정리하자면, 성인의 손상된 뇌신경세포 자체는 스스로 재생되기 어렵습니다. 그러나 줄기세포는 새로운 세포를 공급하고, 남아 있는 세포들의 생존과 연결을 돕고, 염증 환경을 개선하는 역할을 통해 뇌 회복에 기여할 가능성이 충분히 있습니다. 다만, 아직은 연구실과 임상시험 단계에 머물러 있으며 실제 치료로 확립되기까지는 시간이 필요합니다.
줄기세포와 뇌 재생
하지만 단순히 세포를 이식하는 것만으로는 충분하지 않습니다. 새로운 세포가 뇌에 자리잡고 살아남으려면, 그들이 안정적으로 머물 수 있는 “토양”이 필요합니다. 그래서 연구자들은 자가조립 펩타이드(RADA16 등) 같은 바이오재료를 활용해, 줄기세포가 잘 정착하고 뇌 조직 속에서 오래 살아남을 수 있는 환경을 만들어 주려 하고 있습니다.
또한 줄기세포로부터 신경세포뿐 아니라 뇌의 면역을 담당하는 미세아교세포(microglia)를 생성해, 손상된 뇌의 염증 반응을 조절하고 재생을 돕는 방법도 활발히 연구되고 있습니다.
줄기세포 치료와 암 발생 위험성
줄기세포는 스스로 분열하고 다양한 세포로 분화할 수 있는 능력을 가지고 있습니다. 이 ‘무한 증식 능력’과 ‘분화 능력’은 치료에서 큰 장점이지만, 동시에 암세포와 닮은 점이 있어 암으로 발전될 위험성을 내포하고 있습니다.
줄기세포 치료는 이론적으로 암 발생 가능성을 내포하고 있습니다. 특히 초기 연구에서는 기형종 같은 종양이 실제로 관찰되기도 했습니다. 그러나 최근에는 기술이 발전하면서 “분화된 세포만 선별해 이식”하거나, 안전성이 높은 성체줄기세포(예: 중간엽줄기세포, MSC)를 사용하는 방식으로 위험성을 줄여가고 있습니다.
즉, 줄기세포 치료의 암 발생 위험은 완전히 사라진 것은 아니지만, 연구자들이 매우 경계하며 관리하는 부분이고, 임상 단계에서는 환자 안전을 최우선으로 두고 철저히 검증하고 있습니다.
연구자들이 줄기세포 치료에서 가장 크게 우려하는 부분은 크게 세 가지로 정리할 수 있습니다. 첫째, 과도한 증식의 위험입니다. 줄기세포는 본래 스스로 증식하는 능력이 뛰어나지만, 이 과정이 제대로 통제되지 않으면 세포가 종양처럼 뭉쳐 자라게 됩니다. 특히 배아줄기세포(ESC)와 같이 분화 잠재력이 큰 세포는 기형종(teratoma)과 같은 종양을 형성할 수 있다는 보고가 있습니다.
둘째는 분화 미완성의 문제입니다. 줄기세포가 목표하는 세포, 예를 들어 신경세포로 완전히 성숙하지 못하고 미분화 상태로 남아 있을 경우, 이 세포들은 불안정하게 행동하며 암세포와 유사한 성질을 보일 수 있습니다. 이는 치료 효과를 저해할 뿐만 아니라 환자의 안전에도 위험을 끼칠 수 있습니다.
셋째는 유전자 변형 과정에서의 위험성입니다. 줄기세포를 유도하거나 배양하는 과정에서 종종 바이러스 벡터나 유전자 조작 기술이 사용되는데, 이 과정에서 예기치 못한 돌연변이가 발생할 가능성이 있습니다. 이러한 돌연변이는 암 발생 위험을 높이는 요인으로 작용할 수 있습니다.
이러한 우려 때문에 연구자들은 줄기세포 치료를 임상에 적용하기 전, 여러 안전장치를 마련하려 노력하고 있습니다. 예를 들어, 줄기세포를 환자에게 이식하기 전에 충분히 원하는 세포 유형으로 분화시켜 미분화 세포가 남지 않도록 하는 방법을 사용합니다. 또한 유전자 편집이나 배양 조건을 개선하여 불필요한 돌연변이가 생기지 않도록 관리합니다. 마지막으로 임상시험에서는 환자를 수년간 추적 관찰하며 종양 발생 여부를 면밀하게 확인해 안전성을 확보하려고 합니다.
즉, 줄기세포 치료에는 분명 잠재적인 암 발생 위험이 존재하지만, 연구자들은 이를 최소화하기 위한 다양한 전략을 통해 안전성을 보완하고 있습니다. 이는 줄기세포 치료가 앞으로 보다 신뢰할 수 있는 임상적 도구로 자리 잡기 위해 반드시 거쳐야 하는 중요한 과정입니다.
기억은 복원될 수 있을까?
그렇다면, 이렇게 줄기세포로 새로운 신경세포가 만들어진다면, 우리가 잃었던 기억도 되찾을 수 있을까요?
안타깝게도 현재 과학은 거기에 도달하지 못했습니다. 기억은 단순한 데이터 파일처럼 저장되는 것이 아니라, 수많은 신경세포들이 얽혀 만든 복잡한 회로망 속에 자리합니다. 따라서 한 번 끊어진 회로를 그대로 되살리는 것은 거의 불가능합니다.
하지만 중요한 점은 기억이 고정된 ‘사진’이 아니라는 사실입니다. 기억은 언제나 다시 쓰이고 재구성되는 ‘이야기’에 가깝습니다. 예를 들어, 한 환자가 과거의 여행 기억을 잃었다고 해봅시다. 가족이 사진을 보여주고 그때의 일을 이야기해 준다면, 환자의 뇌 속에서는 새로운 회로가 형성됩니다. 원래의 기억을 그대로 불러온 것은 아니지만, 주변 사람들의 기억을 빌려 새로운 기억이 만들어지는 것이지요.
치매환자의 문제점은 자신의 기억과 주변사람들간의 기억이 일치하지 않는다는 것에 있습니다. 건강한 신경 줄기세포가 건강한 뇌세포를 형성한다면 세로운 기억들이 만들어지면서 조각난 기억들을 연결할 확률이 생길 수 있다고 기대할 수 있습니다. 결국 기억은 개인만의 것이 아니라, 가족과 공동체가 함께 이어가는 집단적 경험입니다. 줄기세포 치료로 회복된 뇌는 바로 이 외부의 기억 조각들을 받아들여, 잃어버린 시간을 대신할 새로운 이야기를 다시 써 내려갈 수 있게 될지도 모릅니다.
재생의학의 가능성
줄기세포 치료가 당장 내일 알츠하이머를 완치하게 해주지는 못합니다. 하지만 분명한 것은, 과거에는 상상조차 하지 못했던 방법으로 뇌를 회복시키려는 연구가 진행되고 있다는 점입니다.
마치 잘린 나무가 새싹을 틔우듯, 줄기세포는 뇌 속에서 새로운 회로망을 만들어내고, 그 속에서 우리는 또 다른 방식으로 기억을 이어갈 수 있습니다. 언젠가 줄기세포 치료가 치매 환자에게 “잃어버린 이야기의 다음 장”을 선물하는 날이 올지도 모릅니다.
다음 편 예고
10화. 인공지능, 뇌 질환도 진단할 수 있을까?
해시태그
#줄기세포치료 #재생의학 #알츠하이머치료 #기억회복 #기억을지키는과학
3분 명상
잃어버린 기억은 끊어진 회로 같지만,
줄기세포는 새 회로를 이어주네.
신경의 숲에 다시 빛이 흐르면,
망각의 어둠에 길을 밝힌다.